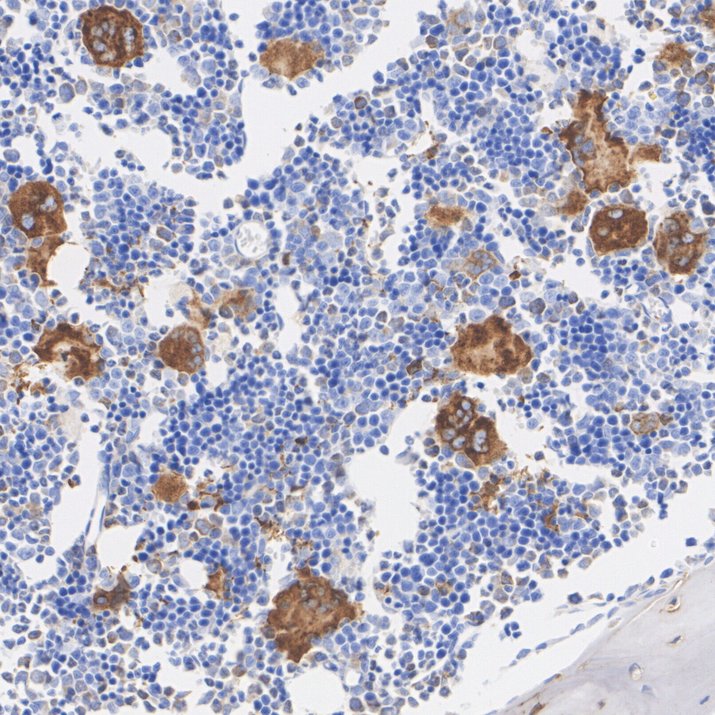

Safety datasheet
Overview
Product Name
TGF beta 1 Recombinant Rabbit Monoclonal Antibody [PSH18-59]
Antibody Type
Recombinant Rabbit monoclonal Antibody
Immunogen
Recombinant protein within human TGF beta 1 aa 1-390.
Species Reactivity
Human, Mouse, Green monkey
Validated Applications
WB, IF-Cell, IHC-P, FC
Molecular Weight
Predicted band size: 44 kDa
Positive Control
K-562 cell lysate, Raji cell lysate, Saos-2 cell lysate, 786-0 cell lysate, COS-1 cell lysate, NIH/3T3 cell lysate, RAW264.7 cell lysate, K-562, NIH/3T3, mouse bone marrow tissue, mouse spleen tissue, rat bone marrow tissue, rat spleen tissue.
Conjugation
unconjugated
Clone Number
PSH18-59
Reactivity Data
Tested Verified (internally validated)
Published Reported in literature (not internally validated)
Predicted Predicted reactive (based on sequence homology)
Not recommended Not recommended (failed internal validation)
| WB | IF-Cell | IHC-P | FC | |
|---|---|---|---|---|
| Human |
|
|
|
|
| Mouse |
|
|
|
|
| Green Monkey |
|
|||
| Rat |
|
|
|
|
Product Features
Form
Liquid
Concentration
Storage Instructions
Shipped at 4℃. Store at +4℃ short term (1-2 weeks). Store at -20℃ long term.
Storage Buffer
1*PBS (pH7.4), 0.1% BSA, 40% Glycerol, 0.2% Proclean 950.
Isotype
IgG
Purification Method
Protein A affinity purified.
Application Dilution
-
WB
-
1:5,000
-
IF-Cell
-
1:100-1:200
-
IHC-P
-
1:3,000-1:5,000
-
FC
-
1:1,000
Target
Function
Transforming growth factor beta 1 or TGF-β1 is a polypeptide member of the transforming growth factor beta superfamily of cytokines. It is a secreted protein that performs many cellular functions, including the control of cell growth, cell proliferation, cell differentiation, and apoptosis. In humans, TGF-β1 is encoded by the TGFB1 gene. TGF-β is a multifunctional set of peptides that controls proliferation, differentiation, and other functions in many cell types. TGF-β acts synergistically with transforming growth factor-alpha (TGF-α) in inducing transformation. It also acts as a negative autocrine growth factor. Dysregulation of TGF-β activation and signaling may result in apoptosis. Many cells synthesize TGF-β and almost all of them have specific receptors for this peptide. TGF-β1, TGF-β2, and TGF-β3 all function through the same receptor signaling systems. TGF-β1 was first identified in human platelets as a protein with a molecular mass of 25 kilodaltons with a potential role in wound healing. It was later characterized as a large protein precursor (containing 390 amino acids) that was proteolytically processed to produce a mature peptide of 112 amino acids. TGF-β1 plays an important role in controlling the immune system, and shows different activities on different types of cell, or cells at different developmental stages. Most immune cells (or leukocytes) secrete TGF-β1.
Background References
1. Takahara T. et. al.TGFB1 mRNA expression is associated with poor prognosis and specific features of inflammation in ccRCC. Virchows Arch. 2022 Feb
2. Abdel Mouti M. et. al. TGFB1/INHBA Homodimer/Nodal-SMAD2/3 Signaling Network: A Pivotal Molecular Target in PDAC Treatment. Mol Ther. 2021 Mar
Subcellular Location
Extracellular matrix, Secreted.
Synonyms
Cartilage-inducing factor antibody
CED antibody
Differentiation inhibiting factor antibody
DPD1 antibody
LAP antibody
Latency-associated peptide antibody
Prepro transforming growth factor beta 1 antibody
TGF beta 1 antibody
TGF beta antibody
TGF beta 1 protein antibody
ExpandCartilage-inducing factor antibody
CED antibody
Differentiation inhibiting factor antibody
DPD1 antibody
LAP antibody
Latency-associated peptide antibody
Prepro transforming growth factor beta 1 antibody
TGF beta 1 antibody
TGF beta antibody
TGF beta 1 protein antibody
TGF-beta 1 protein antibody
TGF-beta-1 antibody
TGF-beta-5 antibody
TGF-beta1 antibody
TGFB antibody
Tgfb-1 antibody
tgfb1 antibody
TGFB1_HUMAN antibody
TGFbeta antibody
TGFbeta1 antibody
Transforming Growth Factor b1 antibody
Transforming Growth Factor beta 1 antibody
Transforming growth factor beta 1a antibody
transforming growth factor beta-1 antibody
transforming growth factor, beta 1 antibody
Transforming Growth Factor-ß1 antibody
CollapseImages
-

Western blot analysis of TGF beta 1 on different lysates with Rabbit anti-TGF beta 1 antibody (HA724012) at 1/5,000 dilution.
Lane 1: K-562 cell lysate
Lane 2: Raji cell lysate
Lane 3: Saos-2 cell lysate
Lane 4: 786-0 cell lysate
Lane 5: COS-1 cell lysate
Lane 6: NIH/3T3 cell lysate
Lane 7: RAW264.7 cell lysate
Lysates/proteins at 20 µg/Lane.
Predicted band size: 44 kDa
Observed band size: 50 kDa
Exposure time: 3 minutes; ECL: K1801;
4-20% SDS-PAGE gel.
Proteins were transferred to a PVDF membrane and blocked with 5% NFDM/TBST for 1 hour at room temperature. The primary antibody (HA724012) at 1/5,000 dilution was used in primary antibody dilution (K1803) at 4℃ overnight. Goat Anti-Rabbit IgG - HRP Secondary Antibody (HA1001) at 1/50,000 dilution was used for 1 hour at room temperature. -

Immunocytochemistry analysis of K-562 cells labeling TGF beta 1 with Rabbit anti-TGF beta 1 antibody (HA724012) at 1/200 dilution.
Cells were fixed in 4% paraformaldehyde for 15 minutes at room temperature, permeabilized with 0.1% Triton X-100 in PBS for 15 minutes at room temperature, then blocked with 1% BSA in 10% negative goat serum for 1 hour at room temperature. Cells were then incubated with Rabbit anti-TGF beta 1 antibody (HA724012) at 1/200 dilution in 1% BSA in PBST overnight at 4 ℃. Goat Anti-Rabbit IgG H&L (iFluor™ 488, HA1121) was used as the secondary antibody at 1/1,000 dilution. PBS instead of the primary antibody was used as the secondary antibody only control. Nuclear DNA was labelled in blue with DAPI.
Beta tubulin (HA601187, red) was stained at 1/100 dilution overnight at +4℃. Goat Anti-Mouse IgG H&L (iFluor™ 594, HA1126) was used as the secondary antibody at 1/1,000 dilution. -

Immunocytochemistry analysis of NIH/3T3 cells labeling TGF beta 1 with Rabbit anti-TGF beta 1 antibody (HA724012) at 1/100 dilution.
Cells were fixed in 4% paraformaldehyde for 15 minutes at room temperature, permeabilized with 0.1% Triton X-100 in PBS for 15 minutes at room temperature, then blocked with 1% BSA in 10% negative goat serum for 1 hour at room temperature. Cells were then incubated with Rabbit anti-TGF beta 1 antibody (HA724012) at 1/100 dilution in 1% BSA in PBST overnight at 4 ℃. Goat Anti-Rabbit IgG H&L (iFluor™ 488, HA1121) was used as the secondary antibody at 1/1,000 dilution. PBS instead of the primary antibody was used as the secondary antibody only control. Nuclear DNA was labelled in blue with DAPI.
Beta tubulin (HA601187, red) was stained at 1/100 dilution overnight at +4℃. Goat Anti-Mouse IgG H&L (iFluor™ 594, HA1126) was used as the secondary antibody at 1/1,000 dilution. -

Immunohistochemical analysis of paraffin-embedded mouse bone marrow tissue with Rabbit anti-TGF beta 1 antibody (HA724012) at 1/5,000 dilution.
The section was pre-treated using heat mediated antigen retrieval with Tris-EDTA buffer (pH 9.0) for 20 minutes. The tissues were blocked in 1% BSA for 20 minutes at room temperature, washed with ddH2O and PBS, and then probed with the primary antibody (HA724012) at 1/5,000 dilution for 1 hour at room temperature. The detection was performed using an HRP conjugated compact polymer system. DAB was used as the chromogen. Tissues were counterstained with hematoxylin and mounted with DPX. -

Immunohistochemical analysis of paraffin-embedded mouse spleen tissue with Rabbit anti-TGF beta 1 antibody (HA724012) at 1/1,000 dilution.
The section was pre-treated using heat mediated antigen retrieval with Tris-EDTA buffer (pH 9.0) for 20 minutes. The tissues were blocked in 1% BSA for 20 minutes at room temperature, washed with ddH2O and PBS, and then probed with the primary antibody (HA724012) at 1/1,000 dilution for 1 hour at room temperature. The detection was performed using an HRP conjugated compact polymer system. DAB was used as the chromogen. Tissues were counterstained with hematoxylin and mounted with DPX. -
Immunohistochemical analysis of paraffin-embedded rat bone marrow tissue with Rabbit anti-TGF beta 1 antibody (HA724012) at 1/5,000 dilution.
The section was pre-treated using heat mediated antigen retrieval with Tris-EDTA buffer (pH 9.0) for 20 minutes. The tissues were blocked in 1% BSA for 20 minutes at room temperature, washed with ddH2O and PBS, and then probed with the primary antibody (HA724012) at 1/5,000 dilution for 1 hour at room temperature. The detection was performed using an HRP conjugated compact polymer system. DAB was used as the chromogen. Tissues were counterstained with hematoxylin and mounted with DPX. -

Immunohistochemical analysis of paraffin-embedded rat spleen tissue with Rabbit anti-TGF beta 1 antibody (HA724012) at 1/5,000 dilution.
The section was pre-treated using heat mediated antigen retrieval with Tris-EDTA buffer (pH 9.0) for 20 minutes. The tissues were blocked in 1% BSA for 20 minutes at room temperature, washed with ddH2O and PBS, and then probed with the primary antibody (HA724012) at 1/5,000 dilution for 1 hour at room temperature. The detection was performed using an HRP conjugated compact polymer system. DAB was used as the chromogen. Tissues were counterstained with hematoxylin and mounted with DPX. -

Flow cytometric analysis of K-562 cells labeling TGF beta 1.
Cells were fixed and permeabilized. Then stained with the primary antibody (HA724012, 1/1,000) (red) compared with Rabbit IgG Isotype Control (green). After incubation of the primary antibody at +4℃ for an hour, the cells were stained with a iFluor™ 488 conjugate-Goat anti-Rabbit IgG Secondary antibody (HA1121) at 1/1,000 dilution for 30 minutes at +4℃. Unlabelled sample was used as a control (cells without incubation with primary antibody; black).
Please note: All products are "FOR RESEARCH USE ONLY AND ARE NOT INTENDED FOR DIAGNOSTIC OR THERAPEUTIC USE"
Citation
-
Inhalable TFRC-Targeted Extracellular Vesicles Delivery of siTGF-β1 Alleviates Pulmonary Fibrosis via Dual Inhibition of Ferroptosis and Fibroblast Activation
Journal: International Journal Of Nanomedicine
DOI: 10.2147/IJN.S568106
IF: 6.5
Application: WB,IHC
Reactivity: Mouse
Publish date: 2026 Feb
Products with the same target and pathway
TGF beta 1 Rabbit Polyclonal Antibody
Application: WB
Reactivity: Human
Conjugate: unconjugated
Biotin Conjugated TGF beta 1 Recombinant Rabbit Monoclonal Antibody [PSH15-22] - Detector
Application: ELISA(Det),ELISA
Reactivity: Human,Mouse,Rat,Dog,Cynomolgus monkey,Pig
Conjugate: Biotin
TGF beta 1 Recombinant Rabbit Monoclonal Antibody [PSH18-59] - BSA and Azide free
Application: WB,IF-Cell,IHC-P,FC
Reactivity: Human,Mouse,Green monkey
Conjugate: unconjugated
TGF beta 1 Recombinant Rabbit Monoclonal Antibody [PSH15-22] - BSA and Azide free (Detector)
Application: ELISA(Det)
Reactivity: Human,Mouse,Rat,Dog,Cynomolgus monkey,Pig
Conjugate: unconjugated
TGF beta 1 Recombinant Rabbit Monoclonal Antibody [PSH15-21] - BSA and Azide free (Capture)
Application: ELISA(Cap)
Reactivity: Human,Mouse,Rat,Dog,Cynomolgus monkey,Pig
Conjugate: unconjugated
TGF beta 1 Recombinant Rabbit Monoclonal Antibody [PD00-17] - BSA and Azide free
Application: WB,IHC-P,IF-Tissue
Reactivity: Human,Mouse,Rat,Green monkey
Conjugate: unconjugated
TGF beta 1 Mouse Monoclonal Antibody [B2-F6]
Application: WB,IHC-P,FC
Reactivity: Human
Conjugate: unconjugated
TGF beta 1 Recombinant Rabbit Monoclonal Antibody [PD00-17]
Application: WB,IHC-P,IF-Tissue
Reactivity: Human,Mouse,Rat,Green monkey
Conjugate: unconjugated
TGF beta 1 Recombinant Rabbit Monoclonal Antibody
Application: mIHC
Reactivity: Human
Conjugate: unconjugated












